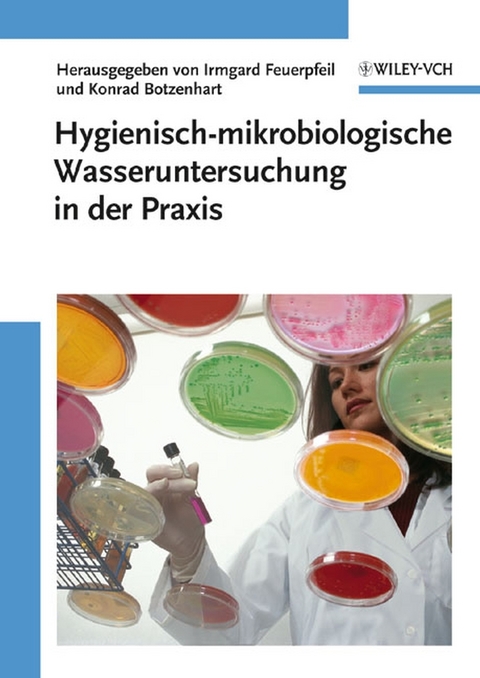
Hygienisch-mikrobiologische Wasseruntersuchung in der Praxis -

Hygienisch-mikrobiologische Wasseruntersuchung in der Praxis
Wiley-VCH (Verlag)
978-3-527-31569-7 (ISBN)
- Titel leider nicht mehr lieferbar
- Artikel merken
Dr. Irmgard Feuerpfeil leitet das Fachgebiet "Mikrobiologie des Trink- und Badebeckenwassers" beim Umweltbundesamt, Außenstelle Bad Elster. Als ehemalige Mitarbeiterin von Dr. Eberhard Schulze hatte Sie bereits maßgeblichen Anteil an seinem 1996 erschienenen Werk "Hygienisch-mikrobiologische Wasseruntersuchungen". Prof. Dr. med. Konrad Botzenhart ist der ehemalige Direktor des Instituts für Allgemeine Hygiene und Umwelthygiene der Universität Tübingen. Sein Spezialgebiet ist die Wasserhygiene, darüberhinaus ist er der Autor mehrerer viel beachteter Bücher zu Themen der Wasser-, Luft- und Krankenhaushygiene.
ALLGEMEINES
METHODISCHE GRUNDLAGEN
Reinigen und Sterilisieren von Labormaterialien
Herstellung und Aufbewahrung von Nährböden
Entsorgung
Entnahme und Transport von Proben
Mikrobiologisches Messen
Vergleichbarkeit von mikrobiologischen Meßmethoden
Nationale/internationale Normung
QUALITÄTSSICHERUNG
Laborakkreditierung
Mikrobiologische Ringversuche zur Qualitätskontrolle im Rahmen der Trinkwasservordnung 2001
BAKTERIOLOGISCHE WASSERUNTERSUCHUNGEN
Koloniezahl
E. coli - coliforme Bakterien
Weitere Enterobakterien (Salmonella, Yersinia)
Salmonellen
Enterokokken
Clostridien
Pseudomonas aeruginosa
Aeromonas
Campylobacter
Legionellen
Atypische Mycobakterien
Nachweis von Vibrio cholerae, Vibrio vulnificus und anderen Vibrio-Arten
VIROLOGISCHE UND PROTOZOOLOGISCHE WASSERUNTERSUCHUNGEN
Bakteriophagen
Enterale oder enteropathogene Viren
Cryptosporidien und Giardien
MOLEKULARBIOLOGISCHE METHODEN
SPEZIFISCHE KRITERIEN
Untersuchung des Einflusses von Werkstoffen auf die Vermehrung von Mikroorganismen im Trink- und Badewasserbereich in der Praxis und im Laborversuch
Bakterienvermehrungspotential
BEWERTUNG
"Alle gängigen mikrobiologischen Nachweismethoden sind hier für den Praktiker zusammengestellt. [...] Unverzichtbar für alle, die Wasseruntersuchungen in Auftrag geben, durchführen oder bewerten wollen."
forum Nachhaltig Wirtschaften (April 2011)
"Alle gängigen Nachweismethoden sind hier für den Praktiker zusammengestellt und in übersichtlichen Schemata erläutert. Nützlich für alle, die Wasseruntersuchungen in Auftrag geben, durchführen oder bewerten wollen."
Korrespondenz Wasserwirtschaft - Wasser Boden Natur (08/08)
"In diesem Buch werden alle gängigen mikrobiologischen Nachweismethoden vorgestellt. Zu jedem Nachweis werden die gesetzlichen Anforderungen und Bewertungsmaßstäbe erläutert, sowohl auf nationaler wie auf EU-Ebene."
LaborPraxis (1.9.08)
"Unserer Meinung nach handelt es sich hier um ein Standardwerk, das in keiner der angesprochenen Institutionen fehlen sollte."
Berufsverband der Hygieneinspektoren BW e.V. - Newsletter
Juni 2008
| Erscheint lt. Verlag | 26.3.2008 |
|---|---|
| Sprache | deutsch |
| Maße | 170 x 240 mm |
| Gewicht | 870 g |
| Themenwelt | Naturwissenschaften ► Chemie ► Technische Chemie |
| Schlagworte | Angewandte Mikrobiologie • Bauingenieur- u. Bauwesen • Biowissenschaften • Chemie • Mikrobiologie • Umweltanalytik • Umweltchemie • Umweltforschung • Umweltwissenschaften • Wasseranalyse • Wasserchemie • Wasseruntersuchung • Wasserversorgung |
| ISBN-10 | 3-527-31569-1 / 3527315691 |
| ISBN-13 | 978-3-527-31569-7 / 9783527315697 |
| Zustand | Neuware |
| Informationen gemäß Produktsicherheitsverordnung (GPSR) | |
| Haben Sie eine Frage zum Produkt? |
aus dem Bereich